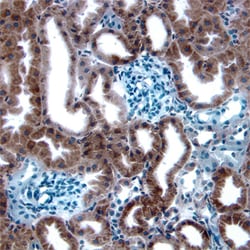
Human/Mouse/Rat MDM2/HDM2 Antibody, R D Systems 100&mu;g; Unlabeled:Antibodies,

missing translation for 'onlineSavingsMsg'
Learn More
Learn More
Human/Mouse/Rat MDM2/HDM2 Antibody, R&D Systems™


Rabbit Polyclonal Antibody has been used in 8 publications
Brand: R&D Systems AF1244
This item is not returnable.
View return policy
Description
MDM2/HDM2 Polyclonal specifically detects MDM2/HDM2 in Human, Mouse, Rat samples. It is validated for Western Blot, Immunohistochemistry.
Specifications
| MDM2/HDM2 | |
| Polyclonal | |
| Unconjugated | |
| Q00987 | |
| MDM2 | |
| E. coli-derived recombinant human MDM2, Asn3-Pro491, Accession # Q00987 | |
| 100 μg | |
| Primary | |
| Detects human, mouse, and rat MDM2. | |
| Human, Mouse, Rat | |
| IgG |
| Western Blot, Immunohistochemistry | |
| LYOPH | |
| Western Blot 1 ug/mL, Immunohistochemistry 3-15 ug/mL | |
| ACTFS, HDM2, HDMX, MDM2 oncogene, E3 ubiquitin protein ligase | |
| Rabbit | |
| Affinity Purified | |
| RUO | |
| 4193 | |
| Reconstitute at 0.2 mg/mL in sterile PBS. | |
| Use a manual defrost freezer and avoid repeated freeze-thaw cycles. 12 months from date of receipt, -20 to -70 degreesC as supplied. 1 month, 2 to 8 degreesC under sterile conditions after reconstitution. 6 months, -20 to -70 degreesC under sterile conditions after reconstitution. |
Product Content Correction
Your input is important to us. Please complete this form to provide feedback related to the content on this product.
Product Title
Spot an opportunity for improvement?Share a Content Correction